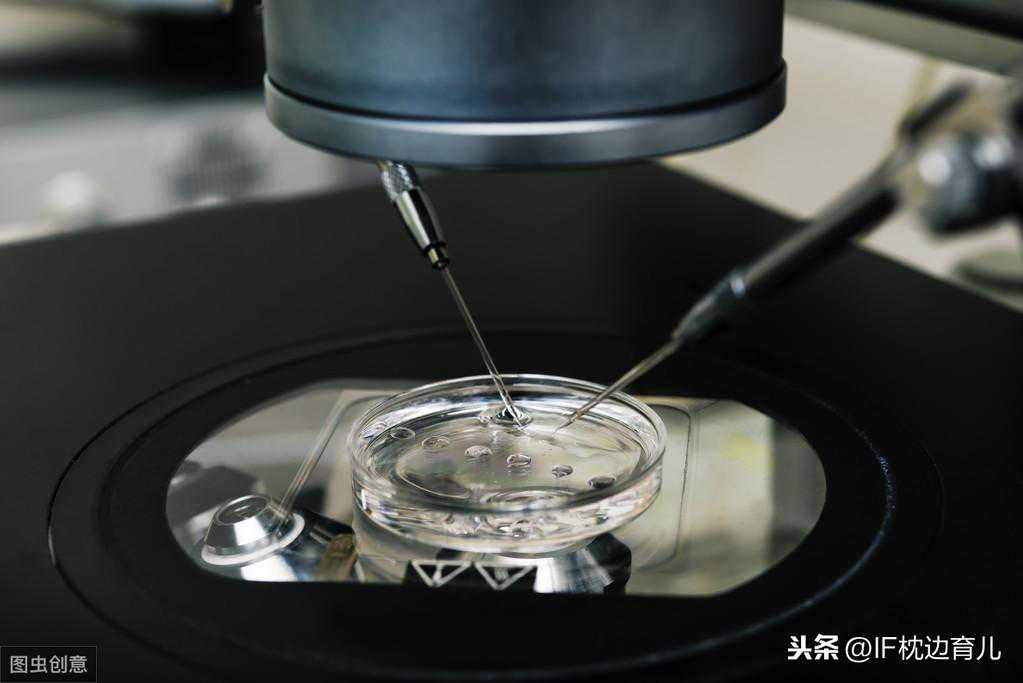

传宗接代一事仿佛在我们国家是根深蒂固的思想了,大部分的家庭都会想要个孩子,只不过古时候没有现在的医学技术,那个时候的女子若是没办法生孩子,那么就会生活的很艰难。而如今,试管婴儿的技术出现,帮助了很多生育上有困难的家庭。

远房表妹因为身体原因,无法在体内完成孕育过程,于是就想到去尝试试管婴儿。跟家里人商量的时候,老人家还以为是宝宝生活在试管里的,等到时机成熟了,从试管里抱回来就可以了。
对于第一次听到试管婴儿的人来说,有这样的联想是很正常的。试管婴儿其实只是把受精卵结合的过程放在体外来进行,等到他们在人工控制的环境下完成受精,那么就会移植到女性子宫里,从而完成孕育过程。
看似简单的操作,实际上没有毅力的人还真的很难坚持完所有的步骤。
•取出卵子
每一位女性每个月只有一次的排卵机会,只有成熟了之后才会排出。要想做试管婴儿,就必须选出成熟卵子里质量比较好的,这样成功率才会更高一些。
为此,医生们会根据不同的体质制定促排卵计划,在此期间女性可能会出现呕吐等反应。取出体内时,会用到一根特制的针,该过程一般会打麻药,所以疼痛感会不那么明显。

•进行结合
在结合之前会综合评估小蝌蚪和卵子的质量,进行优质结合。这也是为什么试管婴儿生出来的孩子更聪明。
美国有专门的工作人员针对传闻做了一个实验,他找到了一批试管婴儿出生成长的孩子,智力发育均在中等水平以上、其中10%智力水平达到超越正常值,没有一个存在发育不良或智力缺陷的情况。
由此可见,胚胎的质量越高,宝宝各方面的发育就会更好一些。

•移植到子宫
这一步也是非常关键的,而且也有一定的概率失败。小洁之前也尝试过试管婴儿,可在移植到子宫之后,胚胎没能成功着床,前段时间的努力也都前功尽弃了。
一般来说,移植到子宫之后的第7天,受精卵才开始准备着床工作,所以有些妈妈也会在这个时期感受到微微刺痛,等到第12天的时候,着床工作基本就结束了,医生判定移植是否成功也都是在第12天之后才能得到结论。
•养胎
当胚胎已经稳稳的在你子宫里生长发育时,那么我们要做的就是安心养胎了。但如果上一步已经失败了,也没有关系,我们可以进行新一轮的准备。

香香看到公告栏有一个小广告,香香就打了上面的电话,咨询之后发现是做试管婴儿的,香香一心想要给家里生个男孩,就鬼迷心窍的和对方约定了面谈的时间。
晚上香香就和闺蜜说自己要生一个大胖小子啦,好在闺蜜心细,问了来龙去脉之后就劝住了香香,小心被骗!并告诉她现在还不允许人为选择性别呢!
相信有不少人都听说过试管婴儿可以选择性别,于是心里就打上了小算盘。
目前我国法律是禁止非医学需要的胎儿性别鉴定和选择性别的人工终止妊娠的。技术上虽然允许,但是国家政策里明文规定了,所以爸爸妈妈们可不要去触犯这项法规。
枕边育儿寄语:
试管婴儿的出现的确帮助了不少家庭,但也希望爸爸妈妈们能合理运用。试管婴儿的过程不仅仅是身体上需要受苦受累,心理上也需要承受一定的压力。







